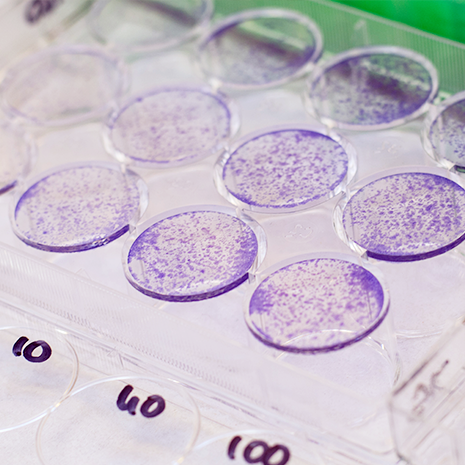
Close up of lab experiment

-

Clinical Pharmacy and
Outcomes SciencesThe Department of Clinical Pharmacy and Outcomes Sciences (CPOS) provides education and training related to professional practice, including application of the pharmaceutical sciences to patient care.
About CPOS
Faculty Directory
-
Drug Discovery and
Biomedical SciencesThe Department of Drug Discovery and Biomedical Sciences (DDBS) provides education and research training to professional and graduate students in the pharmaceutical and biomedical sciences.
About DDBS
Faculty Directory
College of Pharmacy
Departments
University of South Carolina College of Pharmacy includes two academic departments with faculty who are renowned for clinical innovation, patient care, pharmacological research and for empowering students to transform health care globally.